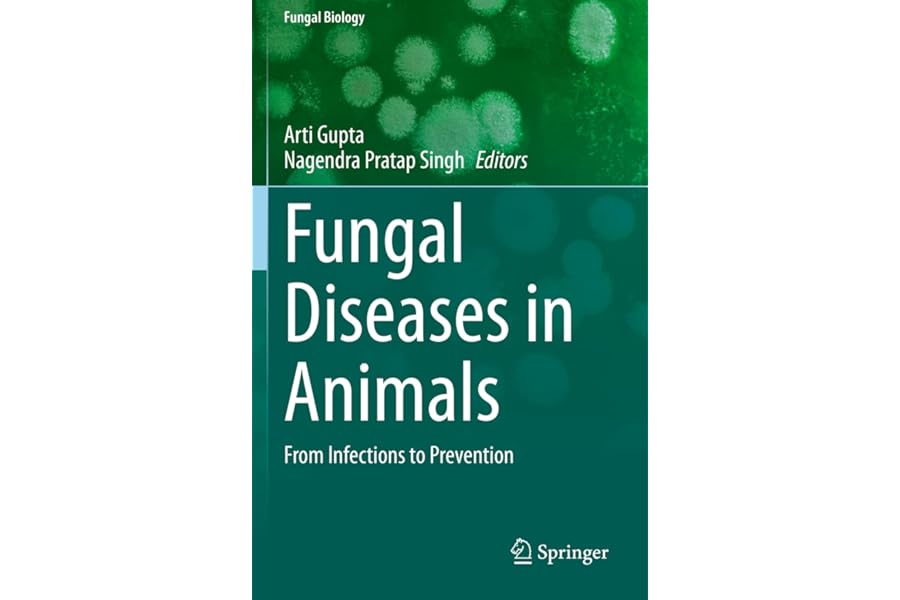
thumbnail

¥25,998Veterinary Microbiology

¥26,573Atlas of Diagnostic Pathology in Nonhuman Primates

¥35,500Microbiome of Finfish and Shellfish

¥14,198Principles of Fish Immunology: From Cells and Molecules to Host Protection

¥17,248Principles of Fish Immunology: From Cells and Molecules to Host Protection

¥28,937Digenetic Trematodes (Advances in Experimental Medicine and Biology, 1454)

¥9,411Handbook of Pathogens and Diseases in Cephalopods

¥32,460Essentials of Laboratory Animal Science: Principles and Practices
¥24,505Fungal Diseases in Animals: From Infections to Prevention (Fungal Biology)
Current Active Category ID: 2573833051